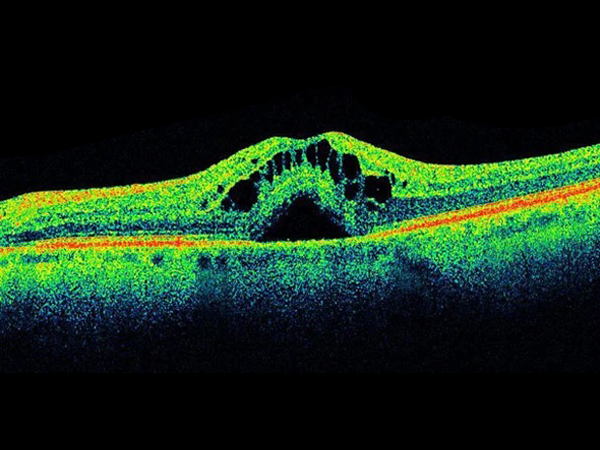
Optical Coherence Tomography (OCT)

Advance Coronary Imaging in Kolkata
Dr. Shuvanan Rayspecialize in advanced Coronary Imaging services, including Intravascular Ultrasound (IVUS), Optical Coherence Tomography (OCT), Fractional Flow Reserve (FFR) assessment, and Resting Full-Cycle Ratio (RFR). These state-of-the-art techniques provide detailed and accurate insights into coronary artery conditions, helping us diagnose blockages, assess the severity of heart disease, and guide precise treatments like stent placement or angioplasty. Our goal is to ensure optimal heart health with cutting-edge imaging solutions tailored to each patient's needs.
Intravascular Ultrasound (IVUS)
IVUS is a revolutionary imaging technique that provides detailed images of the inside of your blood vessels. By using high-frequency sound waves, this procedure allows us to visualize artery walls and detect any blockages or abnormalities. IVUS is critical in assessing the severity of coronary artery disease and guiding treatment options like stent placements or angioplasty.

Optical Coherence Tomography (OCT)
OCT is a high-resolution imaging tool that uses light waves to create incredibly detailed images of coronary arteries. It helps us identify plaque buildup and vessel damage, providing superior clarity compared to traditional imaging techniques. This precise visualization is especially helpful in planning complex coronary interventions and ensuring that procedures like stent placement are done with perfection.
Fractional Flow Reserve (FFR) Assessment
FFR measures the pressure differences across coronary artery stenosis (narrowing) to determine its significance. This real-time assessment helps in deciding whether or not a stent or angioplasty is necessary. By identifying which blockages truly require intervention, FFR helps in reducing unnecessary procedures and improving patient outcomes.
